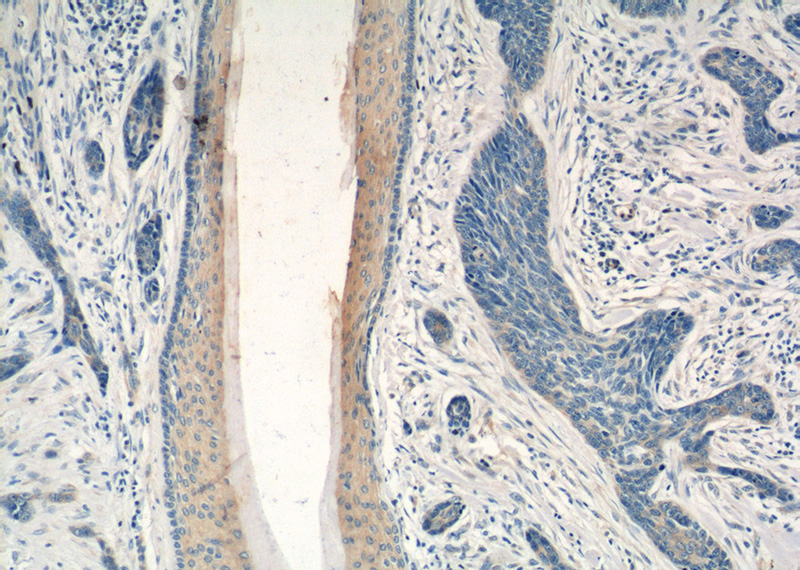
Immunohistochemistry of paraffin-embedded human skin cancer tissue slide using Catalog No:113766(PDCD5 Antibody) at dilution of 1:50 (under 10x lens)
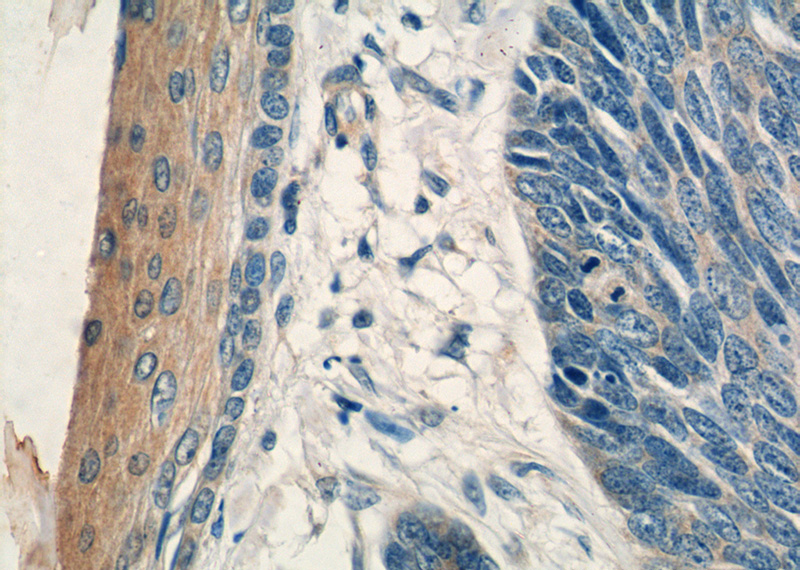
Immunohistochemistry of paraffin-embedded human skin cancer tissue slide using Catalog No:113766(PDCD5 Antibody) at dilution of 1:50 (under 40x lens)

-
Product Name
PDCD5 antibody
- Documents
-
Description
PDCD5 Rabbit Polyclonal antibody. Positive WB detected in human heart tissue, human brain tissue, mouse testis tissue, PC-3 cells. Positive IHC detected in human skin cancer tissue, human colon cancer tissue, human colon tissue. Observed molecular weight by Western-blot: 14 kDa
-
Tested applications
ELISA, WB, IHC
-
Species reactivity
Human,Mouse,Rat; other species not tested.
-
Alternative names
PDCD5 antibody; programmed cell death 5 antibody; Protein TFAR19 antibody; TFAR19 antibody
-
Isotype
Rabbit IgG
-
Preparation
This antibody was obtained by immunization of PDCD5 recombinant protein (Accession Number: NM_004708). Purification method: Antigen affinity purified.
-
Clonality
Polyclonal
-
Formulation
PBS with 0.1% sodium azide and 50% glycerol pH 7.3.
-
Storage instructions
Store at -20℃. DO NOT ALIQUOT
-
Applications
Recommended Dilution:
WB: 1:200-1:2000
IHC: 1:20-1:200
-
Validations

human heart tissue were subjected to SDS PAGE followed by western blot with Catalog No:113766(PDCD5 antibody) at dilution of 1:500
Immunohistochemistry of paraffin-embedded human skin cancer tissue slide using Catalog No:113766(PDCD5 Antibody) at dilution of 1:50 (under 10x lens)
Immunohistochemistry of paraffin-embedded human skin cancer tissue slide using Catalog No:113766(PDCD5 Antibody) at dilution of 1:50 (under 40x lens)
-
Background
PDCD5, also called TFAR19 (TF1 cell apoptosis-related gene 19), was first identified as a gene up-regulated in TF-1 cells under-going apoptosis (PMID: 9920759). PDCD5 can promote pro-grammed cell death in different cell types in response to various stimuli and also enhance TAJ/TROY-induced paraptosis-like cell death (PMID: 15020679). During apoptosis, PDCD5 is rapidly upregulated and translocates from the cytoplasm to nucleus (PMID: 11741587). PDCD5 is a positive regulator of Tip60 and also has a potential ability to interact with p53 (PMID: 22914926, PMID: 19308289). Recent studies have also revealed that PDCD5 may be a suppressor gene and expressed at lower levels in many cancers, including hepatocellular carcinoma, breast cancer, gastric cancer, cervical cancer, lung cancer, astrocytic gliomas, and in leukemia.
-
References
- Bock FJ, Tanzer MC, Haschka MD. The p53 binding protein PDCD5 is not rate-limiting in DNA damage induced cell death. Scientific reports. 5:11268. 2015.
- Choi HK, Choi Y, Park ES. Programmed cell death 5 mediates HDAC3 decay to promote genotoxic stress response. Nature communications. 6:7390. 2015.
- Li K, Zhou Z, Wang YO. Pretreatment of mice with oligonucleotide prop5 protects them from influenza virus infections. Viruses. 6(2):573-81. 2014.
- Xu S, Sui G, Yuan L, Zou Z. Expression of programmed cell death 5 protein inhibits progression of lung carcinoma in vitro and in vivo via the mitochondrial apoptotic pathway. Molecular medicine reports. 10(4):2059-64. 2014.
- Cui X, Choi HK, Choi YS. DNAJB1 destabilizes PDCD5 to suppress p53-mediated apoptosis. Cancer letters. 357(1):307-15. 2015.
- Park SY, Choi HK, Jo SH. YAF2 promotes TP53-mediated genotoxic stress response via stabilization of PDCD5. Biochimica et biophysica acta. 1853(5):1060-72. 2015.
Related Products / Services
Please note: All products are "FOR RESEARCH USE ONLY AND ARE NOT INTENDED FOR DIAGNOSTIC OR THERAPEUTIC USE"
